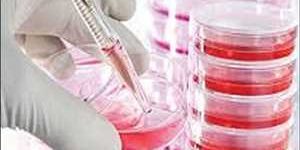

Medios de cultivo celular Crecimiento del mercado, estrategias comerciales y pronóstico para 2030 | Informe exclusivo por hechos y factores
El informe de investigación Medios de cultivo celular es un análisis detallado y dedicado del escenario actual del mercado global Medios de cultivo celular que cubre los diversos aspectos aplicables …